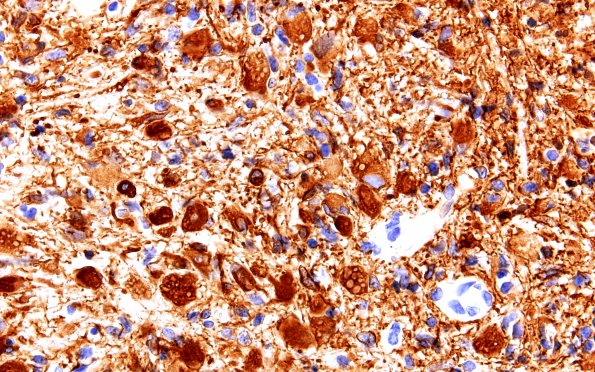
3B4 Glioblastoma, granular cell type (Case 3) GFAP 60X

Table of Contents
Washington University Experience | NEOPLASMS (GLIAL) | Glioblastoma, granular cell type | 3B4 Glioblastoma, granular cell type (Case 3) GFAP 60X
The large granular tumor cells are positive for glial fibrillary acidic protein; however, the actual cytoplasmic granules do not appear to stain. ---- Other stains: An LCA stain shows large numbers of microglial cells in the background. A PAS stain with and without diastase digestion stained some of these cells with diastase resistant material.